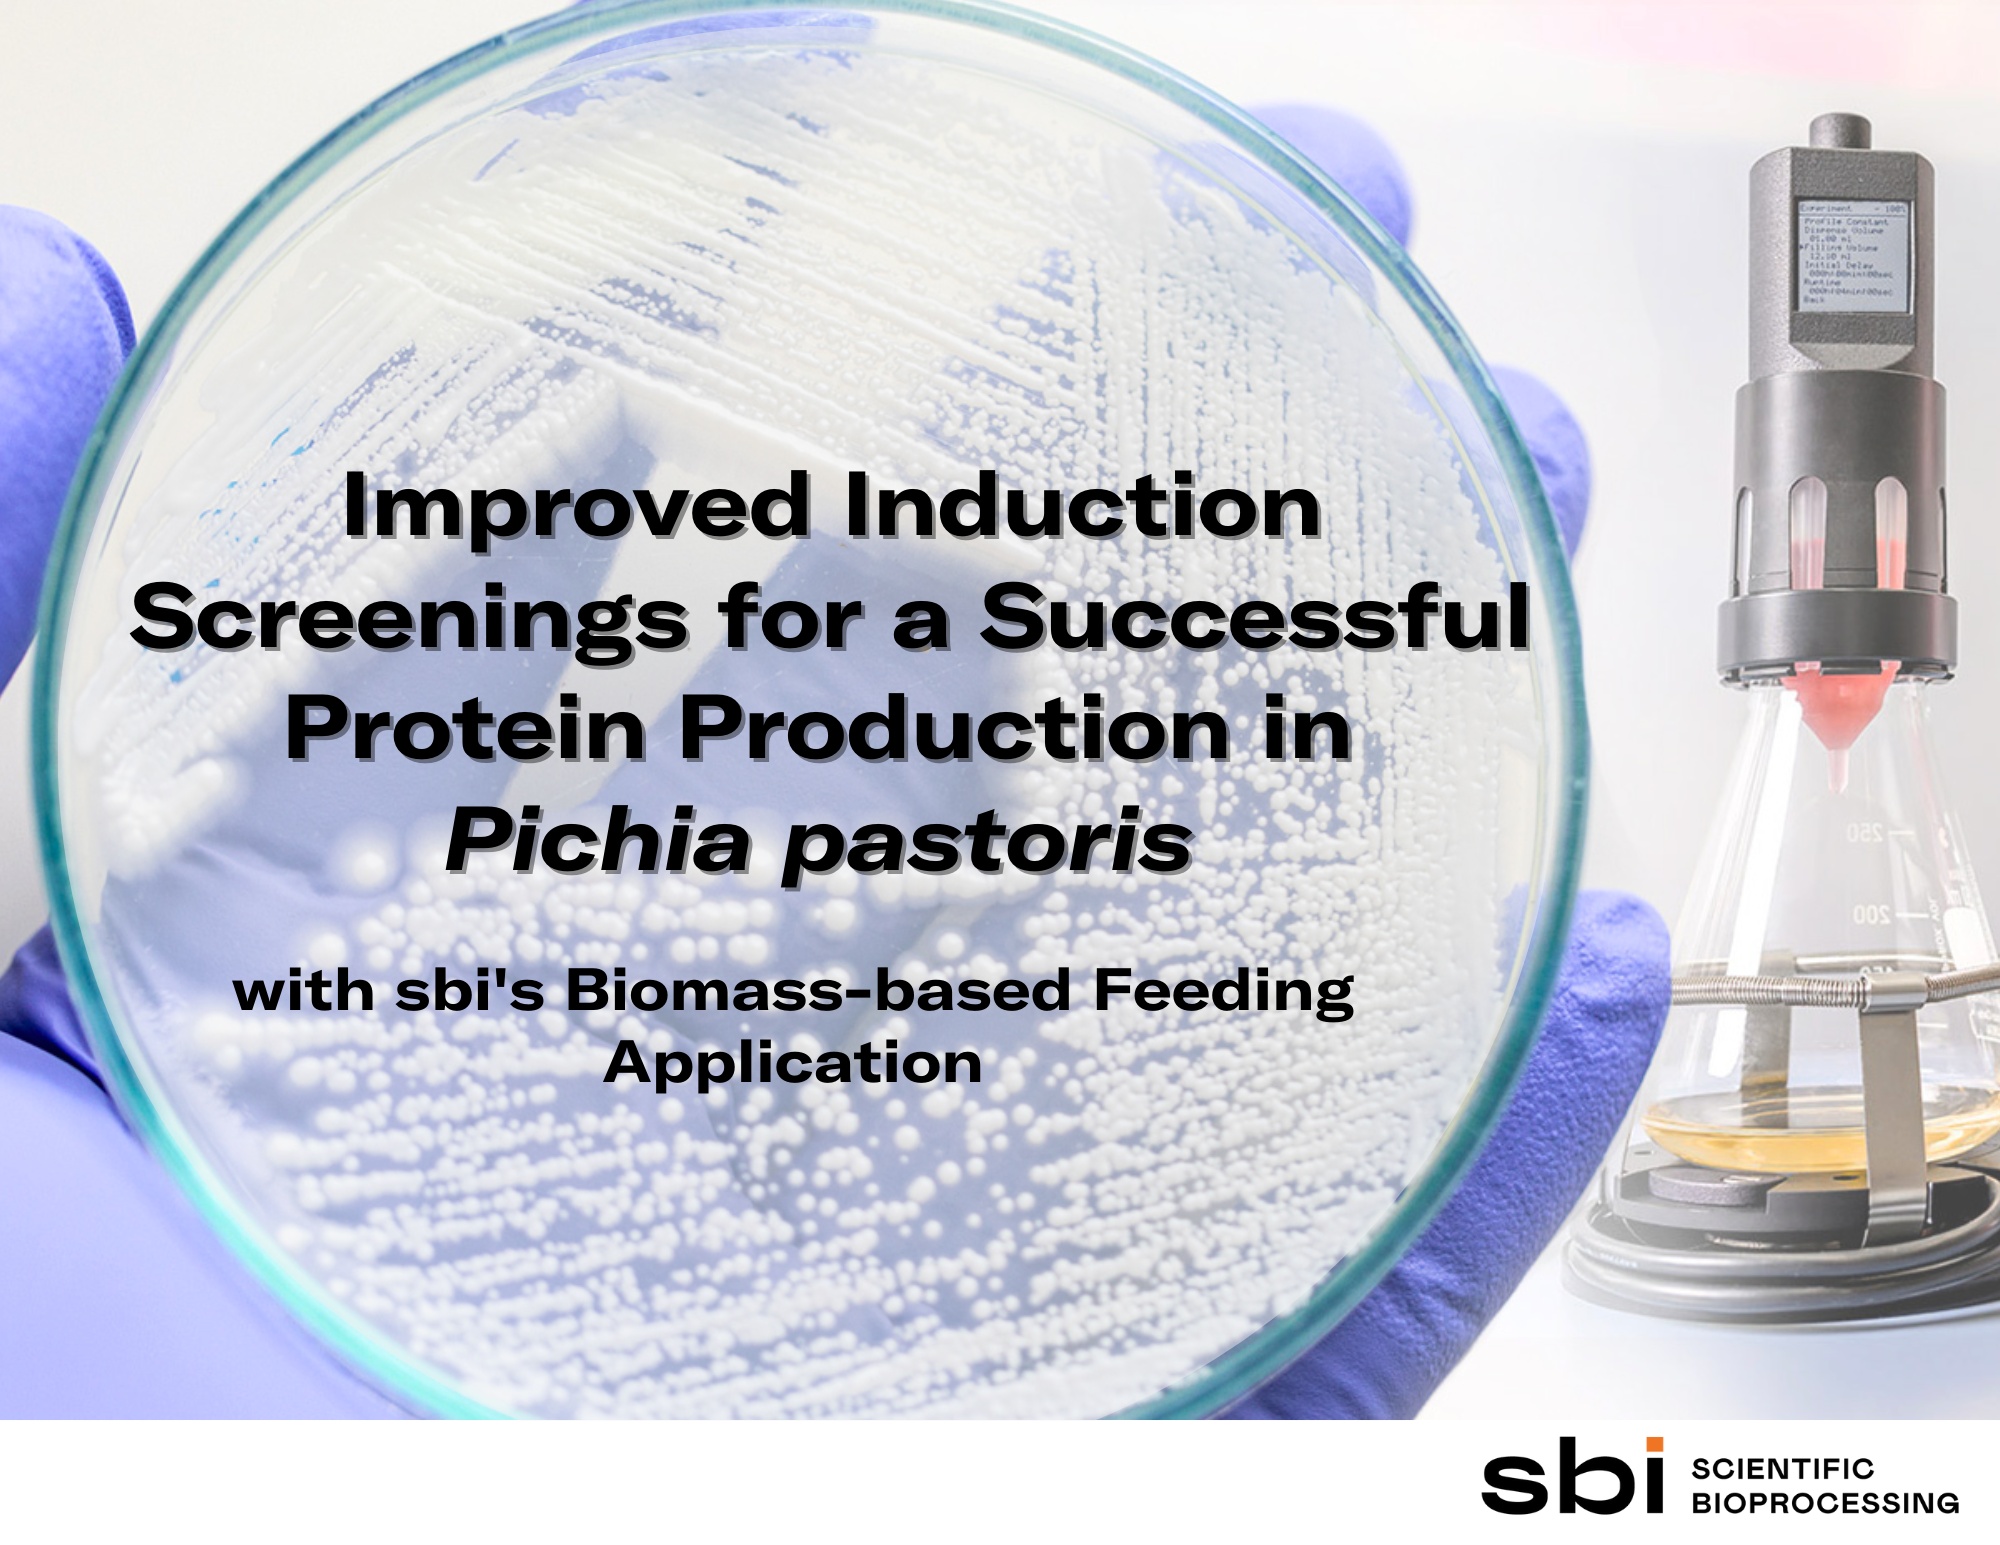
Pichia pastoris - Case Study - sbi

マイストア
変更
お店で受け取る
(送料無料)
配送する
納期目安:
2026.03.16 5:17頃のお届け予定です。
決済方法が、クレジット、代金引換の場合に限ります。その他の決済方法の場合はこちらをご確認ください。
※土・日・祝日の注文の場合や在庫状況によって、商品のお届けにお時間をいただく場合がございます。
Hypocrisy / Penetralia ヒポクリシー Pisticci Flapover Crossbody Bag - Chainlink Leather – Patricia Nashの詳細情報
Pisticci Flapover Crossbody Bag - Chainlink Leather – Patricia Nash。400_front_aff87c24-b8d2-4fe1-。Chobani Flip Chocolate Hazelnut Haze Craze Low-Fat Greek Yogurt。Chobani® Flip® | Chocolate Haze Craze®。ドイツ オリジナル盤返品、コンビニ支払い、受取評価の遅い人お断りデスメタル
ベストセラーランキングです
近くの売り場の商品
カスタマーレビュー
オススメ度 4.7点
現在、2347件のレビューが投稿されています。

.png?width=2000&height=714&name=Pichia pastoris - plate with cells (1).png)






















